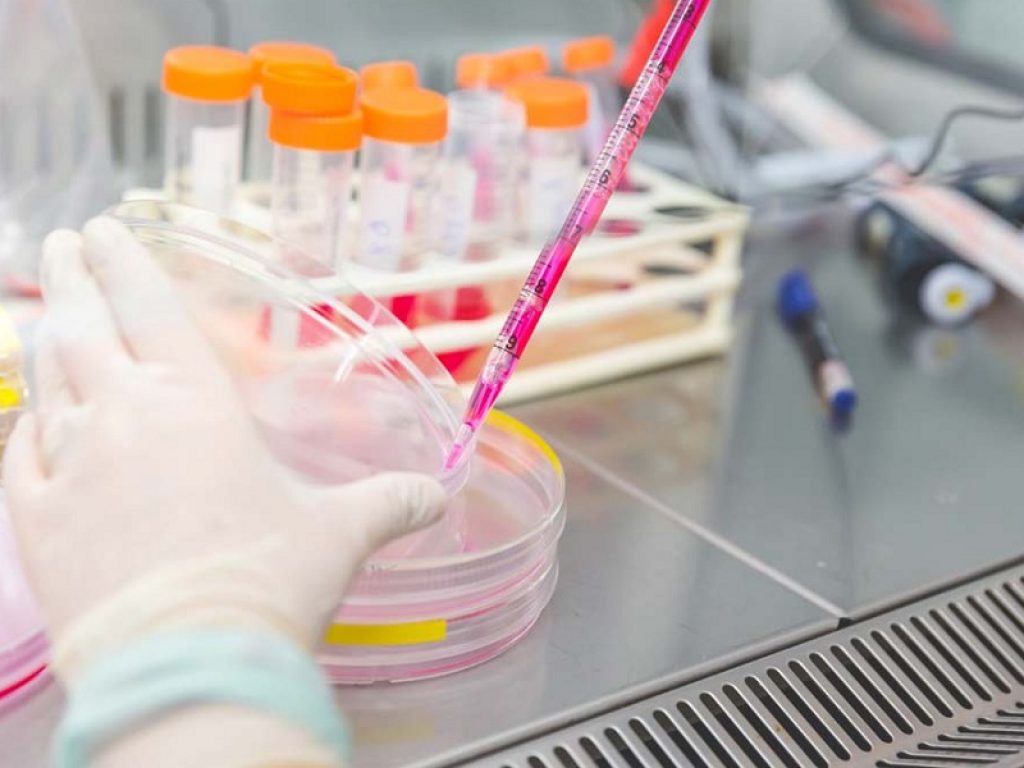
ricerca distrofie muscolari

Malattie neuromuscolari: UILDM chiarisce alcuni dubbi rispetto alla vaccinazione anti-COVID nei bambini e diffonde alcune raccomandazioni sul tema

La Commissione tecnico-scientifica dell’AIFA-Agenzia Italiana del Farmaco ha approvato l’estensione di indicazione dell’utilizzo del vaccino Comirnaty (Pfizer) per la fascia di età compresa tra 5 e 11 anni, con formulazione specifica (pediatrica) e con una dose ridotta (1/3 del dosaggio autorizzato per adulti e adolescenti). La schedula vaccinale prevede la somministrazione di due dosi a distanza di tre settimane l’una dall’altra. A seguito di questo importante aggiornamento, la Commissione medico-scientifica UILDM ha preparato una nota con alcune raccomandazioni sulla vaccinazione anti-COVID per i bambini che soffrono di patologie croniche, incluse le malattie neuromuscolari.
Il vaccino è raccomandato in tutti i casi perché si è mostrato efficace nel ridurre di circa il 91% il rischio di infezione e di prevenire casi severi, sia pur rari, dovuti direttamente al virus o alle sue complicanze infiammatorie. Nel beneficio di una vaccinazione si deve considerare non soltanto la protezione dalla malattia, ma anche la possibilità di frequentare con una maggiore sicurezza la scuola e mantenere gli spazi ricreativi ed educativi, particolarmente importanti per lo sviluppo psichico in questa fascia di età.
La raccomandazione alla vaccinazione è ancora maggiore se il bambino soffre di patologie croniche, incluse le malattie neuromuscolari. Infatti il vaccino aiuta a prevenire possibili effetti più gravi dovuti al COVID-19: è quindi molto più rischioso lasciare un bambino con malattia neuromuscolare senza alcuna protezione. Le controindicazioni sono rarissime e, in ogni caso, i vantaggi della vaccinazione superano i pochissimi rischi. Gli specialisti che seguono il bambino potranno dare utili indicazioni in tal senso.
Per leggere la nota completa clicca qui.